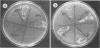
1011

Abstract
Field soybean plants were inoculated with Hup+ wild-type or H2 uptake-negative (Hup−) mutants of Bradyrhizobium japonicum. For two consecutive summers we found an enrichment for acinetobacters associated with the surfaces of the H2-evolving nodules. Soybean root nodules that evolved H2 had up to 12 times more Acinetobacter spp. bacteria associated with their surfaces than did nodules incapable of evolving H2. All of the newly isolated strains identified as Acinetobacter obtained from the surfaces of root nodules, as well as known established Acinetobacter strains, were capable of oxidizing H2, a property not previously described for this alkane-degrading soil bacterium.
Full text
PDF





Images in this article
Selected References
These references are in PubMed. This may not be the complete list of references from this article.
- Baumann P., Doudoroff M., Stanier R. Y. A study of the Moraxella group. II. Oxidative-negative species (genus Acinetobacter). J Bacteriol. 1968 May;95(5):1520–1541. doi: 10.1128/jb.95.5.1520-1541.1968. [DOI] [PMC free article] [PubMed] [Google Scholar]
- Bishop P. E., Guevara J. G., Engelke J. A., Evans H. J. Relation between Glutamine Synthetase and Nitrogenase Activities in the Symbiotic Association between Rhizobium japonicum and Glycine max. Plant Physiol. 1976 Apr;57(4):542–546. doi: 10.1104/pp.57.4.542. [DOI] [PMC free article] [PubMed] [Google Scholar]
- Emerich D. W., Ruiz-Argüeso T., Ching T. M., Evans H. J. Hydrogen-dependent nitrogenase activity and ATP formation in Rhizobium japonicum bacteroids. J Bacteriol. 1979 Jan;137(1):153–160. doi: 10.1128/jb.137.1.153-160.1979. [DOI] [PMC free article] [PubMed] [Google Scholar]
- Henriksen S. D. Moraxella, neisseria, branhamella, and acinetobacter. Annu Rev Microbiol. 1976;30:63–83. doi: 10.1146/annurev.mi.30.100176.000431. [DOI] [PubMed] [Google Scholar]
- Juni E. Genetics and physiology of Acinetobacter. Annu Rev Microbiol. 1978;32:349–371. doi: 10.1146/annurev.mi.32.100178.002025. [DOI] [PubMed] [Google Scholar]
- Juni E. Interspecies transformation of Acinetobacter: genetic evidence for a ubiquitous genus. J Bacteriol. 1972 Nov;112(2):917–931. doi: 10.1128/jb.112.2.917-931.1972. [DOI] [PMC free article] [PubMed] [Google Scholar]
- Keyser H. H., Weber D. F., Uratsu S. L. Rhizobium japonicum Serogroup and Hydrogenase Phenotype Distribution in 12 States. Appl Environ Microbiol. 1984 Apr;47(4):613–615. doi: 10.1128/aem.47.4.613-615.1984. [DOI] [PMC free article] [PubMed] [Google Scholar]
- Keyser H. H., van Berkum P., Weber D. F. A Comparative Study of the Physiology of Symbioses Formed by Rhizobium japonicum with Glycine max, Vigna unguiculata, and Macroptilium atropurpurem. Plant Physiol. 1982 Dec;70(6):1626–1630. doi: 10.1104/pp.70.6.1626. [DOI] [PMC free article] [PubMed] [Google Scholar]
- La Favre J. S., Focht D. D. Conservation in soil of h(2) liberated from n(2) fixation by hup nodules. Appl Environ Microbiol. 1983 Aug;46(2):304–311. doi: 10.1128/aem.46.2.304-311.1983. [DOI] [PMC free article] [PubMed] [Google Scholar]
- Maier R. J., Merberg D. M. Rhizobium japonicum mutants that are hypersensitive to repression of H2 uptake by oxygen. J Bacteriol. 1982 Apr;150(1):161–167. doi: 10.1128/jb.150.1.161-167.1982. [DOI] [PMC free article] [PubMed] [Google Scholar]
- Maier R. J. Rhizobium japonicum mutant strains unable to grow chemoautotrophically with H2. J Bacteriol. 1981 Jan;145(1):533–540. doi: 10.1128/jb.145.1.533-540.1981. [DOI] [PMC free article] [PubMed] [Google Scholar]
- Merberg D., O'Hara E. B., Maier R. J. Regulation of hydrogenase in Rhizobium japonicum: analysis of mutants altered in regulation by carbon substrates and oxygen. J Bacteriol. 1983 Dec;156(3):1236–1242. doi: 10.1128/jb.156.3.1236-1242.1983. [DOI] [PMC free article] [PubMed] [Google Scholar]
- Miller R. W., Sirois J. C. Relative Efficacy of Different Alfalfa Cultivar-Rhizobium meliloti Strain Combinations for Symbiotic Nitrogen Fixation. Appl Environ Microbiol. 1982 Apr;43(4):764–768. doi: 10.1128/aem.43.4.764-768.1982. [DOI] [PMC free article] [PubMed] [Google Scholar]
- Schubert K. R., Evans H. J. Hydrogen evolution: A major factor affecting the efficiency of nitrogen fixation in nodulated symbionts. Proc Natl Acad Sci U S A. 1976 Apr;73(4):1207–1211. doi: 10.1073/pnas.73.4.1207. [DOI] [PMC free article] [PubMed] [Google Scholar]
- Simpson F. B., Burris R. H. A nitrogen pressure of 50 atmospheres does not prevent evolution of hydrogen by nitrogenase. Science. 1984 Jun 8;224(4653):1095–1097. doi: 10.1126/science.6585956. [DOI] [PubMed] [Google Scholar]
- Stults L. W., O'Hara E. B., Maier R. J. Nickel is a component of hydrogenase in Rhizobium japonicum. J Bacteriol. 1984 Jul;159(1):153–158. doi: 10.1128/jb.159.1.153-158.1984. [DOI] [PMC free article] [PubMed] [Google Scholar]
- Wang R., Healey F. P., Myers J. Amperometric measurement of hydrogen evolution in chlamydomonas. Plant Physiol. 1971 Jul;48(1):108–110. doi: 10.1104/pp.48.1.108. [DOI] [PMC free article] [PubMed] [Google Scholar]
- Wong T. Y., Maier R. J. H2-dependent mixotrophic growth of N2-fixing Azotobacter vinelandii. J Bacteriol. 1985 Aug;163(2):528–533. doi: 10.1128/jb.163.2.528-533.1985. [DOI] [PMC free article] [PubMed] [Google Scholar]